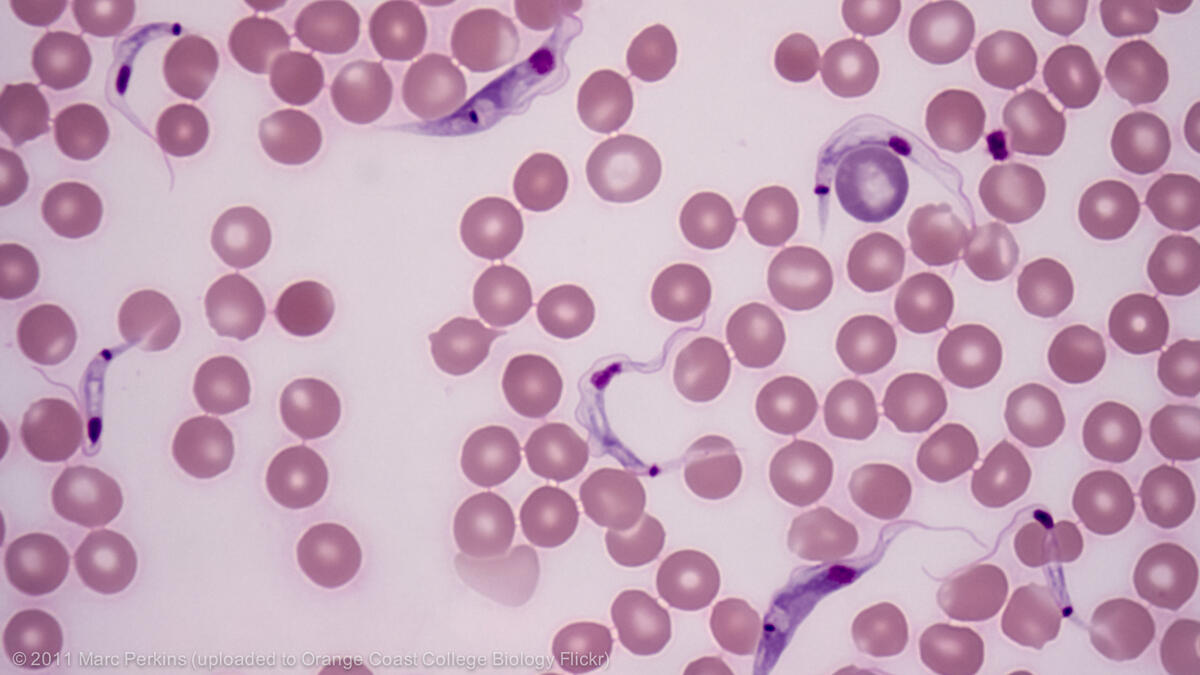

The Cochrane Infectious Diseases Group (CIDG) editorial base is located at the Liverpool School of Tropical Medicine in Liverpool, UK.

Over 600 authors from some 52 countries contribute to the preparation of the Cochrane Reviews. They are supported by an international team of Editors, each with topic or methodological expertise.Since 1994, the CIDG has been preparing systematic reviews on the benefits and harms of healthcare interventions for infectious diseases, particularly malaria, tuberculosis, diarrhoea, and tropical diseases. As of 2015, we now also manage the HIV/AIDS portfolio of reviews.
The editorial base for the Cochrane Infectious Diseases Group is funded by UKaid from the Foreign, Commonwealth & Development Office (FCDO).
Website: